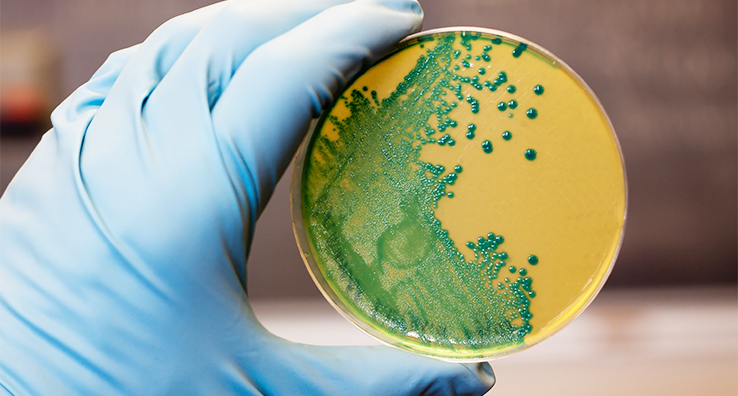

Discovery of New Listeria Species and Its Effect on EMPs
Researchers at Cornell University have identified five new species of listeria in agricultural soil in the United States. The discovery is expected to help food manufacturers improve food safety by identifying potential new growth niches that previously may have been overlooked. And it could further help them understand the differences between pathogenic listeria and the non-pathogenic species.
However, for this to happen, food manufacturers must now spring into action. Standard identification protocols currently used by the industry must be evaluated, and food manufacturers around the world should take this opportunity to take a fresh look at their Environmental Monitoring Program (EMP).
These new developments present the timely opportunity to assess your EMP program team and their technical education. Many companies find that by properly training their EMP team, they can be more proactive and effective in finding and addressing potential bacteria contamination risks.
Intertek Alchemy provides a Food Safety Professional eLearning library that includes resources to help food safety professionals develop and manage EMPs. The advanced professional-level courses are geared to individuals who administer, participate or contribute to food safety programs. And it includes valuable insights and expertise from the experienced Alchemy Food Safety Consulting team.
The eLearning content features three in-depth modularized courses focusing on environmental monitoring, risk assessment, and verification and validation. The environmental monitoring course teaches professionals how to establish an EMP and distinguishes the different regulatory requirements in the U.S. and abroad.
It details required sanitation controls, explains how to implement and manage testing protocols, covers septic sampling techniques, and distinguishes the different pathogens in food processing environments.
Also, it explores software solutions to manage and trend results while demonstrating how to document corrective actions and trend results, which is required by many regulations and GFSI audit requirements.
While it’s critical to train food safety professionals on how to identify and prevent listeria contaminations, you can’t forget about frontline workers. They are the ever-present eyes and ears of the food production process.
Intertek Alchemy offers courses to help frontline workers prevent food contaminations including the basics of environmental monitoring to a complete overview of listeria. For example, our environmental monitoring basics course educates employees on the continuous process of identifying dangerous microorganisms within a facility, the all-important ‘why’ we have an EMP and how to maintain the environment to prevent conditions for bacteria growth.
Having your frontline workers clearly understand operational hazards is critical to a strong food safety culture. Our listeria course for frontline workers explains the different types of listeria species, the dangers and the important steps employees can take to prevent it from spreading.
While the discovery of these new listeria strains hold promise of a safer food supply, it will also reset how our food safety professionals and frontline workers address environmental pathogen risks.
Details on Intertek Alchemy frontline worker training can be found here.
If you have general questions or insight into the new listeria species, please add to the conversation in the comments below.
